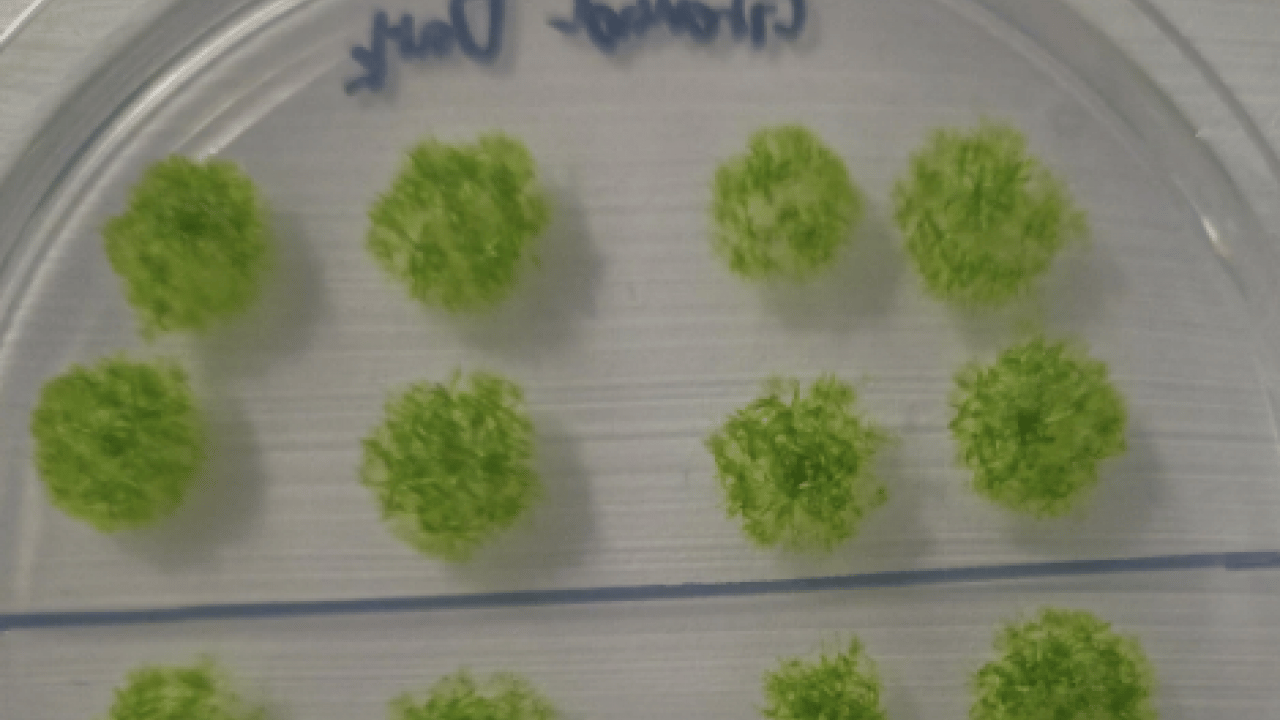
Foto - Bilim insanları tarihi teste imza attı! Mars'ta tarıma bir adım daha: 9 ay boyunca uzay boşluğuna dayandı

Bilim insanları tarihi teste imza attı! Mars'ta tarıma bir adım daha: 9 ay boyunca uzay boşluğuna dayandı
Japon bilim insanları, yosun sporofitlerini uzay boşluğuna göndererek dikkat çeken tarihi bir teste imza attı.
Milli İradenin Sesi Yeni Akit
Türkiye ve dünyadaki gelişmeleri yakından takip etmek için Google listenize Yeni Akit'i ekleyin.
Japon bilim insanları, yosun sporofitlerini uzay boşluğuna göndererek dikkat çeken tarihi bir teste imza attı.
Uluslararası Uzay İstasyonu'nun dış yüzeyinde 283 gün boyunca kozmik radyasyona ve vakum ortamına maruz bırakılan yosun sporlarının yüzde 80'inden fazlası canlı kalarak, bir kara bitkisinin uzayda uzun süre hayatta kalabileceğini kanıtladı.
Himalayalar'dan aktif volkanlara kadar dünyanın en zorlu coğrafyalarında yaşayabilen yosunların dayanıklılığı, bilim insanlarını uzay araştırmalarında yeni bir aşamaya taşıdı. Hokkaido Üniversitesi liderliğindeki bir araştırma ekibi, yosun sporofitlerini uzay boşluğuna göndererek tarihi bir dayanıklılık testine imza attı. iScience dergisinde 20 Kasım'da yayımlanan sonuçlara göre, Uluslararası Uzay İstasyonu'nun (ISS) dışında dokuz ay geçiren sporların büyük çoğunluğu dünyaya canlı döndü ve üreme yeteneklerini korudu.
Araştırma fikri, yosunların Dünya üzerindeki en ekstrem ortamlarda kolonileşme yeteneğinden yola çıkılarak geliştirildi. Hokkaido Üniversitesi'nden araştırmanın baş yazarı Tomomichi Fujita ve ekibi, Physcomitrium patens türü toprak yosununu uzaya göndermeden önce laboratuvar ortamında simüle edilmiş uzay koşullarına tabi tuttu. Yüksek UV radyasyonu, aşırı sıcaklık dalgalanmaları ve vakum ortamını içeren testlerde; genç yosun (protenemata), yavru hücreleri ve sporofit (kapsüllenmiş sporlar) olmak üzere üç farklı yapı incelendi.
Yapılan ön testlerde, genç yosunların yüksek UV ve aşırı sıcaklıklara dayanamadığı, yavru hücrelerinin ise kısmi başarı gösterdiği belirlendi. Buna karşın, kapalı spor yapısına sahip sporofitlerin UV radyasyonuna yaklaşık 1.000 kat daha fazla tolerans gösterdiği saptandı. Araştırmacılar, sporu çevreleyen yapının fiziksel ve kimyasal bir bariyer görevi görerek UV radyasyonunu emdiğini ve iç sporu koruduğunu tespit etti. Ekip, bu dayanıklılığın bitkilerin 500 milyon yıl önce sudan karaya geçişini sağlayan evrimsel bir adaptasyon olabileceğini öne sürdü. Sporların laboratuvar ortamında -196°C soğuğa ve 55°C sıcağa uzun süre dayanabildiği kaydedildi.
Bu bulguların ardından Mart 2022'de Cygnus NG-17 uzay aracıyla ISS'ye gönderilen yüzlerce sporofit örneği, istasyonun dışına yerleştirildi. Toplam 283 gün boyunca uzay boşluğunda kalan örnekler, Ocak 2023'te SpaceX CRS-16 ile dünyaya geri getirildi. Fujita, insanların aksine yosun sporlarının bu koşullarda canlılığını korumasının, yaşamın hücresel düzeyde uzay koşullarına dayanacak içsel mekanizmalara sahip olduğunun kanıtı olduğunu belirtti. Analizler sonucunda, sporların yüzde 80'inden fazlasının hayatta kaldığı ve laboratuvarda yeniden çimlenebildiği görüldü. Klorofil a seviyelerinde yüzde 20'lik bir azalma tespit edilmesine rağmen, bu durumun bitkilerin sağlığını ve üreme kapasitesini etkilemediği raporlandı.
Araştırma ekibi, elde edilen verilerle oluşturdukları matematiksel modelde, kaplı sporların uzay koşullarında teorik olarak 15 yıla kadar hayatta kalabileceğini öngördü. Ancak uzmanlar, bu tahminin kesinleşmesi için daha geniş veri setlerine ihtiyaç duyulduğunu vurguladı. Çalışmanın sonuçlarının, Ay ve Mars gibi dünya dışı ortamlarda ekosistemlerin kurulması ve uzay tarımı sistemlerinin geliştirilmesi adına önemli bir veri kaynağı oluşturması hedefleniyor.
WhatsApp İhbar Hattı
+90 (553) 313 94 23